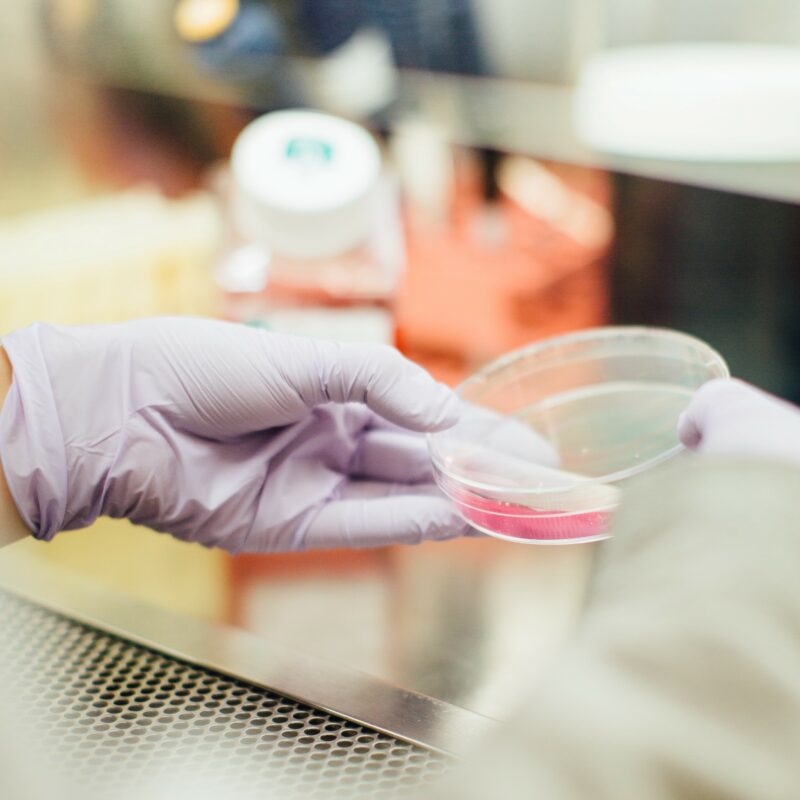

Welsh universities change lives with artificial intelligence and data science
Welsh Government investment in universities collaborating in data science and artificial intelligence is changing lives and helping Wales become an international leader in the field. As part of the Digital Strategy for Wales, £500,000 of funding is being shared between 22 innovative projects.
Wales Data Nation Accelerator (WDNA) is a collaboration between Cardiff, Swansea, Aberystwyth and Bangor universities to help Wales secure long-term data science and AI success.
As data science and AI become more widespread, university research teams are helping people across Wales by ensuring projects are being taken forward with industry so the outcomes can be adopted to improve economic returns, quality of life and sustainability. At the same time this will support creating a skilled and digitally competent workforce.
Professor Matthias Eberl and his team in the School of Medicine at Cardiff University will use AI to save lives by preventing sepsis in abdominal surgery patients. Welsh Government funding has helped them work with partners to support their research.
Investing in this kind of research can help resolve challenges particularly affecting Wales. Aberystwyth University are supporting the agricultural sector by using AI to quickly identify parasites common in grazing livestock in Wales due to our climate.
Bangor University are supporting our environment by developing software tools to deploy radar technology along the Welsh coastline. This will provide marine renewable developers, ports and local authorities with valuable, real-time information about the waves and currents in our coastal waters. This research will help find better sites for renewable energy and improve safety.
Minister for Education and Welsh Language, Jeremy Miles said:
“Wales is home to fantastic higher education research. It is great to see our universities working together to make sure Wales is on the forefront of developments in data science and artificial intelligence.
“I am pleased that this funding has helped support projects with the power to improve people’s lives here in Wales and further afield.
“WDNA is an example of how a strong higher education sector can support all aspects of our lives and make sure we’re prepared for the future.”
Minister for Economy, Vaughan Gething said:
“Research, science, and technology has never been more important in terms of supporting solution-focussed projects and outcomes to tackle the major global problems of our time.
“I am confident this new funding will support our universities, working with industry partners, to use the very latest technological innovation in data science and artificial intelligence to do just that.
“In doing so, they will help boost the Welsh economy by helping to create the industries of the future, which will generate the new high-quality jobs we want to see across Wales.”
Professor Roger Whitaker, Pro Vice-Chancellor elect for Research, Innovation and Enterprise, at Cardiff University said:
“The world is changing at an unprecedented pace due to data science and artificial intelligence. This affects almost every sector in Wales. The Universities of Cardiff, Swansea, Bangor, and Aberystwyth have partnered to form the Wales Data Nation Accelerator (WDNA) project, an ambitious programme of research, innovation and training to support digital transformation.
“Welsh Government funding for short term ‘sprint’ projects has enabled partnership with organisations and companies to quickly demonstrate the power and potential of data and AI-driven technologies. This is supporting better health and wellbeing, improved public services, a competitive economy and a greener planet.”

Responses